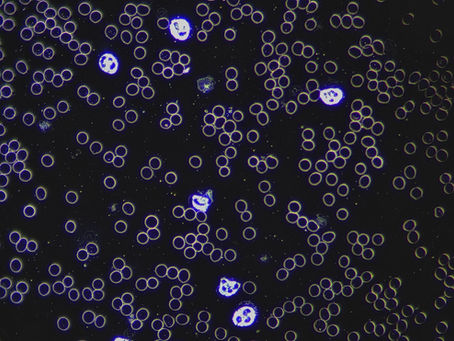
Das Universum in dir — Was Dunkelfeld-Vitalblut Beobachtung sichtbar macht.

top of page
All Posts


Die Kraft der Schwingung: Wie Phonophorese und heilende Frequenzen Körper und Geist in Einklang bringen
Stellen Sie sich vor, Ihr Körper ist ein hochkomplexes Musikinstrument. Im hektischen Alltag, durch Stress, Krankheiten oder emotionale Belastungen, kann dieses Instrument leicht verstimmen. Genau hier setzt die faszinierende Welt der Phonophorese an. Durch den gezielten Einsatz von therapeutischen Stimmgabeln und spezifischen Frequenzen können Sie Ihren Körper im wahrsten Sinne des Wortes wieder "stimmen". Aber was genau verbirgt sich hinter diesem Begriff, und warum haben b
Olivia Haas
23. Mai4 Min. Lesezeit


Infrarotwärme: tiefe Entspannung durch Wärme, Durchblutung und Parasympathikus-Aktivierung
Wärme ist eines der ältesten und zugleich wissenschaftlich am besten erklärbaren Mittel, um den Körper in Richtung Entspannung zu führen. Infrarotwärme unterscheidet sich dabei vor allem durch die Art, wie Wärme erzeugt und im Gewebe ankommt: Sie erwärmt nicht primär die Luft, sondern wird als Strahlung aufgenommen und in Wärme umgewandelt. Das kann als besonders angenehm empfunden werden – und es passt zu dem, was wir aus der Thermophysiologie über Gefäßreaktionen, Muskelton
Olivia Haas
13. Mai4 Min. Lesezeit

Das Universum in dir — Was Dunkelfeld-Vitalblut Beobachtung sichtbar macht.
Eine Momentaufnahme des inneren Milieus — und wie sie mein Leben verändert hat. Was ist Dunkelfeld-Mikroskopie? Die meisten Menschen kennen das klassische Blutbild vom Hausarzt. Zahlen, Werte, Referenzbereiche — alles im grünen Bereich, heißt es. Und trotzdem fühlt man sich nicht gut. Die Dunkelfeld-Mikroskopie geht einen anderen Weg. Dabei wird ein einziger Tropfen Frischblut — direkt aus der Fingerbeere — unter einem speziellen Mikroskop betrachtet, das mit Seitenlicht arb
Olivia Haas
6. Apr.3 Min. Lesezeit


Entdecken Sie die transformative Kraft von EFT – Emotionale Freiheit durch sanftes Klopfen!
Stress, Ängste und belastende Erinnerungen können unser Leben stark beeinflussen. Oft fühlen wir uns gefangen in negativen Gefühlen, ohne zu wissen, wie wir sie loslassen können. Hier setzt EFT (Emotional Freedom Techniques) an – eine einfache, aber wirkungsvolle Methode, die emotionale Blockaden löst und innere Ruhe fördert. In diesem Beitrag erfahren Sie, wie EFT funktioniert, wofür es eingesetzt wird und wie Sie es selbst anwenden können. Das Gefühl innerer Freiheit Wie fu
Olivia Haas
24. März2 Min. Lesezeit


Wie Sie Ihr Wohlbefinden steigern – holistische Stressbewältigungstechniken
Stress, innere Blockaden und das Gefühl, aus dem Gleichgewicht zu geraten – das kennen viele von uns nur zu gut. Gerade in hektischen Zeiten sehnen wir uns nach mehr Ruhe, Energie und Lebensfreude. Genau hier setzt meine Arbeti an. Mit sanften, ganzheitlichen Methoden unterstützt ich Sie dabei, Ihre Selbstheilungskräfte zu aktivieren und wieder in Ihre Balance zu finden. In diesem Beitrag möchte ich Ihnen zeigen, wie Sie mit holistischen Stressbewältigungstechniken Ihr Wohlbe
Olivia Haas
17. März3 Min. Lesezeit


Ganzheitliche Gesundheit fördern: Entdecken Sie die Vorteile von Kinesiologie und Biofeedback
Was bedeutet ganzheitliche Gesundheit? Gesundheit ist weit mehr als die Abwesenheit von Krankheit. Sie ist ein dynamisches Zusammenspiel aus körperlichem Wohlbefinden, mentaler Stärke und emotionaler Balance. Der ganzheitliche Ansatz betrachtet den Menschen in seiner gesamten Komplexität – Körper, Geist und Seele werden nicht getrennt behandelt, sondern als ein zusammenhängendes System verstanden. Immer mehr Menschen suchen heute nach Methoden, die über die klassische Schulme
Olivia Haas
10. März4 Min. Lesezeit


Die wundersame Kraft der Atmung
Wir atmen etwa 20.000 Mal pro Tag – und bemerken es kaum. Dabei ist der Atem eines der mächtigsten Werkzeuge, das wir besitzen. Das Nervensystem verstehen: Gaspedal vs. Bremse Unser autonomes Nervensystem hat zwei „Modi": Sympathikus – das Gaspedal. Er schaltet bei Stress, Gefahr oder Aufregung ein: Herzrasen, Anspannung, Cortisol-Ausschüttung. Der Körper ist bereit zum Kämpfen oder Fliehen. Parasympathikus – die Bremse. Er sorgt für Erholung, Verdauung, Heilung und tiefe R
Olivia Haas
6. März2 Min. Lesezeit
bottom of page